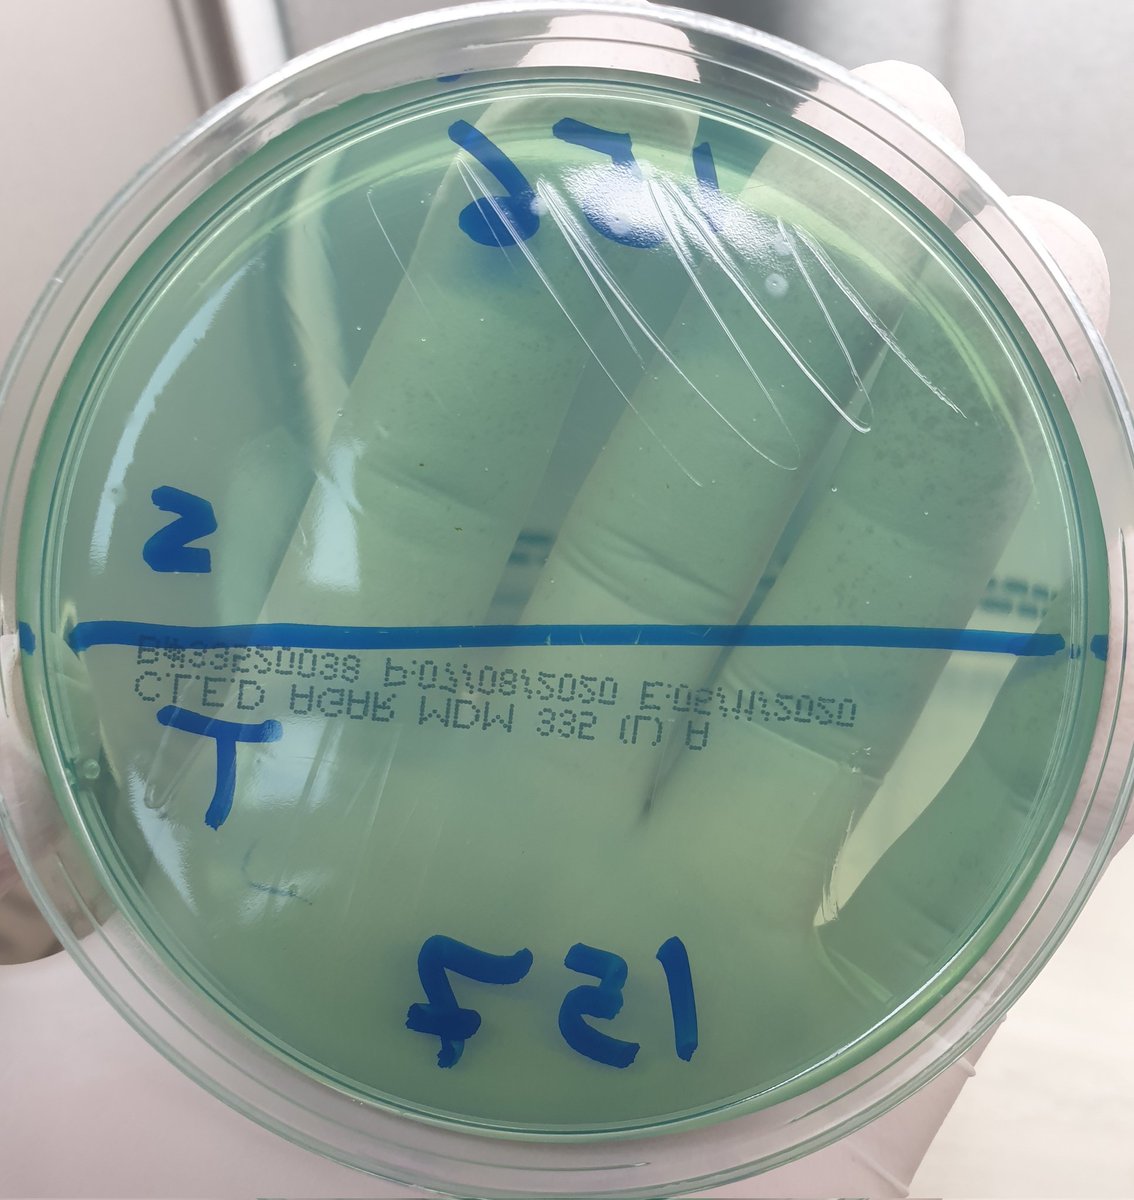

تعرفون إنه ال
Macconkey agar is a selective medium
بينمي ال gram negative
ويقتل ال gram positive
وفي نفس الوقت هو
Indicator (differential) medium
يعني بيعطي ألوان للبكتريا اللي بتنمو عليه ويقسمها إلى
Lactose fermenter لونها وردي
Non Lactose fermenter لونها شفاف غالبا
👍👍
Macconkey agar is a selective medium
بينمي ال gram negative
ويقتل ال gram positive
وفي نفس الوقت هو
Indicator (differential) medium
يعني بيعطي ألوان للبكتريا اللي بتنمو عليه ويقسمها إلى
Lactose fermenter لونها وردي
Non Lactose fermenter لونها شفاف غالبا
👍👍
وتعرفون إن
Blood agar
تنمو عليه
both gram positive and gram negative bacteria
وإنه لذلك لا يعتبر
Selective medium
والسؤال الآن
CLED
يعتبر شبه مين فيهم؟🤔
Blood or Macconkey?
Blood agar
تنمو عليه
both gram positive and gram negative bacteria
وإنه لذلك لا يعتبر
Selective medium
والسؤال الآن
CLED
يعتبر شبه مين فيهم؟🤔
Blood or Macconkey?
الحقيقة إنه ال CLED
يجمع بين مزايا ال
Blood and Macconkey
لأنه ببسمح بنمو البكتريا كلها زي ال
Blood agar
وفي نفس الوقت بيعطينا ألوان نقدر نفرق من خلالها بين ال
Lactose fermenters لونها أصفر
Non fermenters لونها شفاف غالبا
ودول اول ميزتين لل CLED 💪💪
يجمع بين مزايا ال
Blood and Macconkey
لأنه ببسمح بنمو البكتريا كلها زي ال
Blood agar
وفي نفس الوقت بيعطينا ألوان نقدر نفرق من خلالها بين ال
Lactose fermenters لونها أصفر
Non fermenters لونها شفاف غالبا
ودول اول ميزتين لل CLED 💪💪
الميزة الثالثة إنه على عكس ال
Blood agar
لما كنا بنشوف عليه نمو ل
Proteus spp
بتلاقيها عاملة مشكلة كبيرة ومغطية على أي نمو تاني بسبب انها بتعمل
Swarming
لكن ال CLED بيمنع حدوث ال
Swarming
💪
Blood agar
لما كنا بنشوف عليه نمو ل
Proteus spp
بتلاقيها عاملة مشكلة كبيرة ومغطية على أي نمو تاني بسبب انها بتعمل
Swarming
لكن ال CLED بيمنع حدوث ال
Swarming
💪
الميزة الرابعة انه زي ما أنتم عارفين انه عينة ال
Urine
بتمر على ال urethra
وأحيانا على ال skin وهي نازلة
فهيكون فيها شوية
Non pathogenic flora
ال CLED بيموت ال
Normal flora
دي
ولذلك هو مناسب جدا لعينات البول
💪💪💪💪
Urine
بتمر على ال urethra
وأحيانا على ال skin وهي نازلة
فهيكون فيها شوية
Non pathogenic flora
ال CLED بيموت ال
Normal flora
دي
ولذلك هو مناسب جدا لعينات البول
💪💪💪💪
لمزيد من الشرح والتفصيل في التعامل مع ال
Urine culture
هتلاقوا مجموعة محاضرات على قناة اليوتيوب
من خلال الرابط
Systemic microbiology: youtube.com
Urine culture
هتلاقوا مجموعة محاضرات على قناة اليوتيوب
من خلال الرابط
Systemic microbiology: youtube.com
جاري تحميل الاقتراحات...